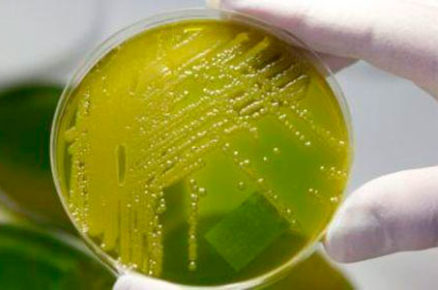
post-image

El pequeño, de 10 años, llamó a un familiar que vivía cerca porque, después de escuchar discutir a sus padres, su padre se había...
Read MoreSucesos
Sucesos
Vigo al minuto
Author N. FernándezPosted on
Hizo ademán de parar después de que una patrulla que estaba realizando un control rutinario le diera el alto por un giro indebido, pero...
Read More
Destacados
Sucesos
Author N. FernándezPosted on
Agentes del Cuerpo Nacional de la Comisaría de Vigo detuvieron a dos varones a los que pillaron “in fraganti” cuando estaban robando en el...
Read More
Sucesos
Vigo al minuto
Author N. FernándezPosted on
Dos mujeres y un hombre fueron atropellados durante la jornada de ayer en Vigo, aunque en los tres casos los arrollados resultaron heridos leves....
Read More
Author Antonio AlbaladejoPosted on
Un joven de 26 años de edad ha resultado herido grave tras caerse a la calle desde la fachada de la Catedral de Lugo....
Read More